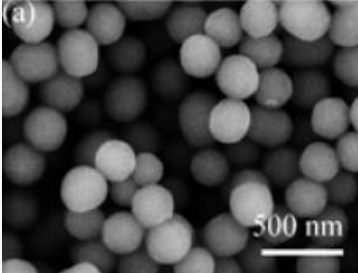

非晶TiO2-十六胺复合球粉体
非晶TiO2-十六胺复合球粉体
| 货号 | 规格 | 数量 | 价格 |
|---|---|---|---|
| Q-0078618 | 100mg |
1
|
询价 |
| Q-0078618 | 250mg |
1
|
询价 |
| Q-0078618 | 500mg |
1
|
询价 |
| Q-0078618 | 1g |
1
|
询价 |
| Q-0078618 | 5g |
1
|
询价 |
快速订购/大包装咨询
张惠宁销售经理

业务范围:AIE材料 | 荧光产品 | MOF产品 | 二维纳米 | 糖化学 | 凝集素 | PEG
如该产品产生售后问题,请联系我们:
产品介绍
西安齐岳生物科技有限公司生产销售“非晶TiO2-十六胺复合球粉体”“非晶TiO2-十六胺复合球粉体”,该产品仅用于科研,如果需要请联系我们
| 参数信息 | |
|---|---|
| 外观状态: | 固体或粉末 |
| 质量指标: | 95%+ |
| 溶解条件: | 有机溶剂/水 |
| CAS号: | N/A |
| 分子量: | N/A |
| 储存条件: | -20℃避光保存 |
| 储存时间: | 1年 |
| 运输条件: | 室温2周 |
| 生产厂家: | 西安齐岳生物科技有限公司 |
相关产品
-
水溶性石墨烯表面修饰抗体是一种在石墨烯纳米片表面通过化学或物理方法固定抗体分子的功能性纳米材料。
-
水溶性石墨烯表面修饰功能性小分子是一种在石墨烯纳米片表面通过化学修饰引入亲水性和功能性小分子的纳米材料。
-
TiO2介孔球粉体,尺寸150nm
-
碳包覆TiO2@CNT粉体




 17778955912
17778955912 1521565887
1521565887 1521565887@qq.com
1521565887@qq.com 官方微信
官方微信 官方微博
官方微博